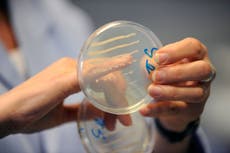
Common mouth bacteria found to ‘melt’ certain cancers in ‘surprising’ discovery

Bacteria in your mouth might reveal how depressed you are, scientists say
Researchers at NYU say they’ve found a link between the mental health condition and less diversity of bacteria in the mouth
Depression could be linked to a lack of diversity in the bacteria in your mouth, according to new research.
As you read this, your mouth contains between 500 billion and 1 trillion bacteria. After the gut microbiome, the orifice is the second-largest community of microorganisms in human bodies.
Now, researchers at New York University say the makeup of those microbes could be used to help diagnose and treat depression. In a new study, they found that less diversity of microbes in the mouth is associated with the mental health condition.
“It’s possible that the oral microbiome influences depressive symptoms through inflammation or changes to the immune system. Conversely, depression can drive changes including dietary intake, poor oral hygiene, increased smoking and drinking, or the use of medications—all of which have the potential to alter the oral microbiome,” Dr. Bei Wu, vice dean for research at NYU Rory Meyers College of Nursing, said in a statement. “We need more research to understand the direction and underlying pathways of this relationship.”
Wu is the senior author of the study, which was published this week in the journal BMC Oral Health.

To reach these conclusions, the authors examined data from the Centers for Disease Control and Prevention’s National Health and Nutrition Examination Survey. They used questionnaire data from more than 15,000 adults collected between 2009 and 2012 to compare symptoms of depression with saliva samples.
They also used gene sequencing to identify the microbes in the saliva and measure the diversity of the oral microbiome. That’s how they found that people with less microbial diversity were more likely to have symptoms of depression.
Additional analysis revealed that practices including smoking, drinking, and dental care influenced the relationship between the oral microbiome and depression. They can all change the makeup of bacteria in the mouth.
They noted that antidepressants and other psychotropic medications have side effects that can lead to reduced saliva and alter the oral microenvironment.
“Thus, medications not only alleviate depressive symptoms but also have a regulatory effect on oral health,” they said.

Still, it remains unclear whether the diversity of microbes in the mouth influences depression, if depression leads to changes in the oral microbiome, or if there’s a symbiotic relationship.
They noted that a recent study found a potential link between depression and the diversity of bacteria in the gut, and that a growing body of research points to a connection between the oral microbiome and overall health. That’s thought to be driven by inflammation and disruptions to the immune system.
They hope these findings will support a greater understanding of the issue. In 2021, an estimated 21 million adults had at least one major depressive episode in the past year.
“Having a better understanding of the relationship between the oral microbiome and depression could not only help us learn about the mechanisms underlying depression, but could contribute to the development of new biomarkers or treatments for mood disorders,” said Wu.
Join our commenting forum
Join thought-provoking conversations, follow other Independent readers and see their replies
Comments

Bookmark popover
Removed from bookmarks